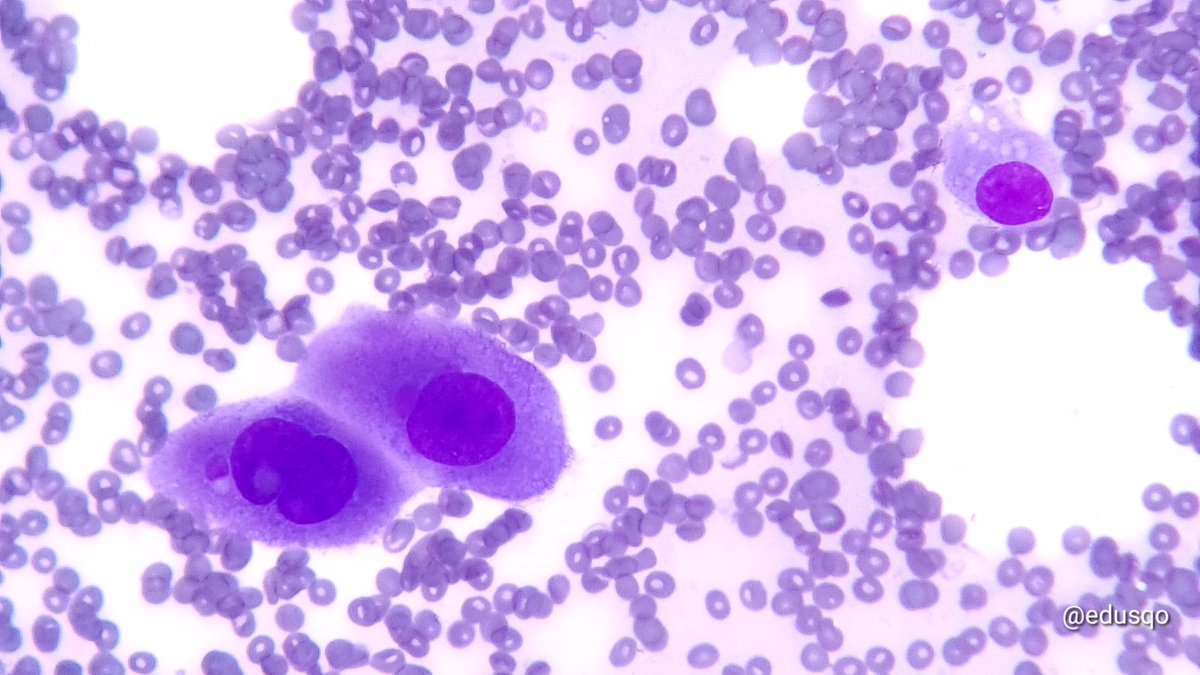
Eduardo Alcaraz, MD PhD tweet media

SLAC - XXX Congreso 2021, Cartagena retweetledi

With ancillary tests and advances in molecular testing, small-volume biopsy has become increasingly popular and helpful, although there are practical limitations.
🔗 acsjournals.onlinelibrary.wiley.com/doi/10.1002/cn…
#CytoPath

English